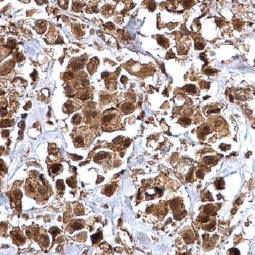
Integrin beta 1 / CD29 antibody (GTX128839)

![]() |
Cancer stem cells (CSCs) are increasingly being recognized as the key determinative cells of malignancies. CSCs are described as relatively quiescent cells capable of self-renewal and the generation of more differentiated daughter cells that constitute the bulk of the tumor mass. While there is still debate as to the existence of a single subset of CSCs versus a collection of CSC variants in some tumors, a growing body of literature links CSCs to all steps of tumorigenesis, from initiation to metastasis. Even more ominously, however, evidence suggests that these cells are responsible for therapeutic resistance and relapse, with their persistence often meaning a poor clinical prognosis. For these reasons, CSC biology has become a vigorously studied area of cancer research.
|
Cancer Stem Cell Markers |
![]() |
|
|
|
Highlighted Products |
|
|
|
|
||||||||||||||||
|
|
||||||||


![SOX2 antibody [GT1876] (GTX627404)](/upload/media/research/Cancer/Cancer_Stem_Cells/GTX627404.jpg)

![CD44 antibody [GT981] (GTX628472)](/upload/media/research/Cancer/Cancer_Stem_Cells/GTX628472.jpg)
![IL3 Receptor alpha antibody [N2C2], Internal (GTX101563)](/upload/media/research/Cancer/Cancer_Stem_Cells/GTX101563.jpg)